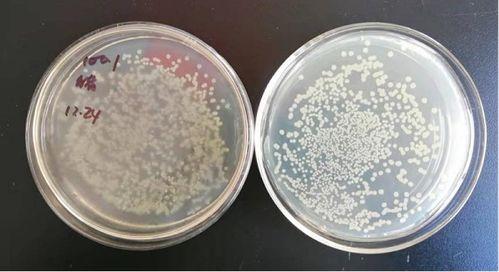
菌落总数测定视频,菌落总数测定方法与步骤详解

网红明星242
-
qq影音合并视频,轻松实现多片段视频一键合成
你有没有想过,有时候几段视频剪辑在一起,效果竟然能变得那么酷炫?没错,今天就要来和你聊聊这个神奇的小技巧——如何使用QQ影音合并视频。别小看了这个功能,它可是能让你的视频瞬间升级,变得更有看头哦!一、什么是QQ影音合并视频?首先,得先弄明白什么是QQ影音合...
-
复仇者纸飞机飞行视频,飞行特技大揭秘
你有没有想过,那些在电影里英勇无畏的复仇者联盟,他们的纸飞机飞行技巧是不是也那么酷炫呢?今天,就让我带你一起揭开这个神秘的面纱,看看这些超级英雄们的纸飞机飞行视频,保证让你大呼过瘾!纸飞机的起源与演变你知道吗,纸飞机的历史可追溯到很久以前。据说,最早的纸飞...
-
亚洲小视频,揭秘亚洲短视频文化的崛起与影响
亲爱的读者,你是否曾在某个闲暇时刻,无意间点开了一个名为“亚洲小视频”的平台?或许你只是好奇地瞥了一眼,又或许你被那些五彩斑斓的短视频深深吸引。今天,就让我们一起走进这个充满活力的世界,揭开“亚洲小视频”的神秘面纱。一、亚洲小视频:一个怎样的平台?亚洲小视...
-
菌落总数测定视频,菌落总数测定方法与步骤详解
你知道吗?在实验室里,有一个神奇的小家伙,它就是菌落总数测定。今天,就让我带你走进这个小小的世界,一起看看它是如何用视频展示自己的风采的!一、菌落总数测定:揭秘实验室的秘密武器菌落总数测定,听起来是不是很专业?没错,它就是实验室里用来检测微生物数量的神器。...
-
莲子视频,探寻莲子背后的营养与养生奥秘
你有没有发现,最近网上突然流行起了一种叫做“莲子视频”的新奇玩意儿?这可不是普通的视频,它可是集合了美食、养生、搞笑等多种元素,让人看了之后忍不住捧腹大笑,又觉得养生知识涨了不少。今天,就让我带你一起来揭秘这个神秘的“莲子视频”世界吧!一、莲子视频的起源...
-
互动视频,开启沉浸式体验的新篇章
你有没有想过,在观看视频的时候,如果视频能和你互动起来,那会是怎样的体验呢?没错,我说的就是互动视频!这种新兴的视频形式,就像是一场精心编排的对话,让你在观看的同时,也能参与到其中,感受前所未有的观影乐趣。今天,就让我带你一起探索这个神奇的世界,看看互动视...
-
刘德华巩俐视频现场,现场视频引热议
你有没有听说最近娱乐圈的大事?没错,就是刘德华和巩俐的视频现场!那场面,简直让人热血沸腾,激动得我一夜没睡好觉。下面就让我带你一起回顾这场精彩绝伦的现场,感受一下那股子激情四溢的气氛吧!一、星光熠熠的舞台那天,刘德华和巩俐来到了一个巨大的体育馆,现场早已座...
-
打疫苗视频,跟随视频了解接种全流程
你知道吗?最近网上有个打疫苗视频,火得一塌糊涂!这不,我就迫不及待地来和你聊聊这个话题,看看这个视频到底有什么魔力,能让那么多人津津乐道。疫苗小课堂:你知道疫苗是什么吗?说起疫苗,可能有些人还不太清楚。简单来说,疫苗就是用来预防某些传染病的特殊药物。它通过...
-
怪异视频,探寻背后隐藏的神秘世界
亲爱的读者们,你是否曾在深夜无聊时,无意间点开了一个怪异视频?那种瞬间心跳加速、好奇心爆棚的感觉,是不是让你欲罢不能?今天,就让我们一起揭开怪异视频的神秘面纱,探索这个充满未知的世界。怪异视频,顾名思义,就是那些让人看了觉得诡异、恐怖、离奇的视频。这些视频...
-
非洲舞蹈视频教学,跟随节奏,感受非洲热情
亲爱的舞者,你是否曾梦想着在非洲大草原上,随着狂野的节奏,挥洒汗水,尽情舞动?现在,机会来了!让我们一起走进非洲舞蹈的世界,通过视频教学,感受那份原始的狂野与热情。准备好了吗?那就跟我一起跳起来吧!一、非洲舞蹈的魅力非洲舞蹈,是一种充满活力、节奏感强烈的舞...